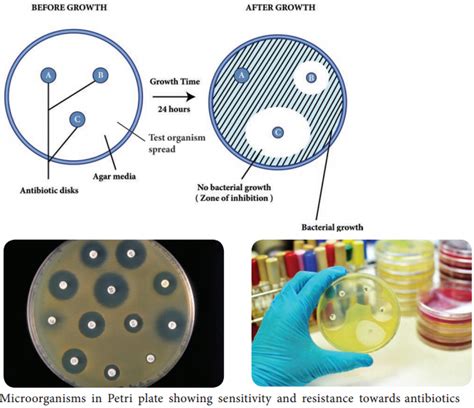

What are the key technologies used in antimicrobial susceptibility testing?
Delve into the various technologies such as automated systems, disk diffusion, and gradient diffusion used in antimicrobial susceptibility testing. Share the advantages, limitations, and future prospects of these technologies in predicting effective antibiotic treatments.
Unraveling the Technologies Behind Antimicrobial Susceptibility Testing
Posted by Rick Ashworth, reviewed by Dr. Miguel Sanchez | 2024-Mar-18
Antimicrobial susceptibility testing (AST) is a crucial diagnostic tool in the fight against infectious diseases. This process helps healthcare providers determine the most effective antibiotic treatment for a patient by evaluating how susceptible a specific pathogen is to various antimicrobial agents. As the challenge of antimicrobial resistance grows, understanding the key technologies involved in AST is more important than ever.
One of the most widely used AST methods is the disk diffusion test. This manual technique involves placing antibiotic-impregnated disks on a culture of the patient's bacteria and measuring the size of the resulting inhibition zone around each disk. The size of the zone indicates the susceptibility of the bacteria to that particular antibiotic. While simple and cost-effective, the disk diffusion method can be labor-intensive and may require subjective interpretation of results.
Another common AST technology is gradient diffusion, exemplified by the E-test. This method utilizes a plastic strip coated with a continuous gradient of antibiotic concentration. When placed on an inoculated agar plate, the gradient allows for a more precise determination of the minimum inhibitory concentration (MIC) - the lowest concentration of an antibiotic needed to inhibit the growth of the bacteria. The E-test provides quantitative MIC data, making it a valuable tool for monitoring antibiotic resistance trends.
For a more automated approach, broth microdilution systems have been developed. These platforms use small, dedicated panels or trays containing predetermined concentrations of various antibiotics. After inoculation with the patient's bacteria, the panels are incubated, and the MIC is determined by observing the lowest concentration that prevents visible bacterial growth. The automated nature of these systems can improve efficiency and standardize the testing process, but they may require a higher initial investment in equipment.
Molecular-based AST methods, such as polymerase chain reaction (PCR) and DNA sequencing, have also emerged as promising technologies. These techniques focus on detecting specific genetic markers associated with antibiotic resistance, rather than relying on growth-based measurements. Molecular AST can provide faster results and may be particularly useful for identifying resistant pathogens in critical care settings. However, these methods may not capture the full complexity of resistance mechanisms and may require specialized expertise and equipment.
Each AST technology offers its own advantages and limitations. Disk diffusion and gradient diffusion are widely accessible and provide valuable qualitative and quantitative data, respectively. Automated broth microdilution systems offer increased efficiency and standardization, while molecular-based methods excel in speed and the ability to detect specific resistance genes. As the field of antimicrobial susceptibility testing continues to evolve, healthcare providers and microbiologists will need to carefully consider the unique needs of their patients and laboratory settings when selecting the most appropriate AST technology.
Looking to the future, researchers are exploring innovative approaches to AST, such as microfluidic devices, mass spectrometry, and machine learning-based analysis. These emerging technologies hold the potential to further enhance the accuracy, speed, and accessibility of antimicrobial susceptibility testing, ultimately supporting the development of targeted and effective antibiotic therapies. As the fight against antimicrobial resistance intensifies, the continuous advancement of AST technologies will be crucial in guiding clinicians towards the most appropriate treatment options and safeguarding public health.
User comments
More Topics to Explore
How does antibiotic resistance affect antimicrobial susceptibility testing?
Discuss the impact of antibiotic resistance on the accuracy of antimicrobial susceptibility testing and the challenges it presents in treating bacterial infections. Share your insights and experiences on this important issue.
How can healthcare professionals improve the accuracy of antimicrobial susceptibility testing results?
Share best practices, strategies, and tips for enhancing the precision and reliability of antimicrobial susceptibility testing outcomes. Discuss the role of proper specimen collection, laboratory techniques, and interpretation of results in optimizing patient care and antibiotic therapy.
What are the emerging trends in antimicrobial susceptibility testing methods?
Explore the latest developments and advancements in antimicrobial susceptibility testing, including genotypic methods, MALDI-TOF mass spectrometry, and rapid molecular techniques. Discuss the potential impact of these novel approaches on enhancing the speed and accuracy of identifying antibiotic-resistant pathogens.
Is there a correlation between biofilm formation and antimicrobial susceptibility testing?
Examine the relationship between biofilm-producing bacteria and their resistance to antimicrobial agents tested in standard susceptibility assays. Discuss the challenges posed by biofilm-associated infections in clinical settings and strategies to address biofilm-mediated antibiotic resistance.
What role does antimicrobial stewardship play in enhancing antimicrobial susceptibility testing?
Discuss the importance of antimicrobial stewardship programs in promoting rational antibiotic use, preserving efficacy, and combating resistance. Share insights on how antimicrobial stewardship initiatives can support accurate antimicrobial susceptibility testing and optimal antibiotic prescribing practices.
How do breakpoints influence the interpretation of antimicrobial susceptibility testing results?
Explain the concept of breakpoints in antimicrobial susceptibility testing and their significance in categorizing bacterial isolates as susceptible, intermediate, or resistant to specific antibiotics. Discuss the role of breakpoints in guiding clinical decision-making regarding antibiotic therapy and treatment outcomes.
What are the challenges in conducting antimicrobial susceptibility testing for atypical pathogens?
Explore the unique challenges and considerations involved in performing susceptibility testing for atypical pathogens like Mycoplasma, Chlamydia, and Legionella. Discuss the limitations of standard testing methods and the importance of tailored approaches to accurately assess antimicrobial susceptibility in these cases.
How can advances in data analytics enhance the accuracy of antimicrobial susceptibility testing?
Explore the potential applications of data analytics, artificial intelligence, and machine learning in improving the precision and efficiency of antimicrobial susceptibility testing. Discuss how predictive modeling and big data analysis can optimize antibiotic selection, dosing regimens, and patient outcomes based on susceptibility test results.
What are the ethical considerations in antimicrobial susceptibility testing and reporting of results?
Reflect on the ethical dilemmas surrounding antimicrobial susceptibility testing, including issues of result interpretation, reporting, confidentiality, and patient autonomy. Discuss the principles of responsible antibiotic stewardship, patient consent, and equitable access to effective treatments in the context of antimicrobial susceptibility testing practices.